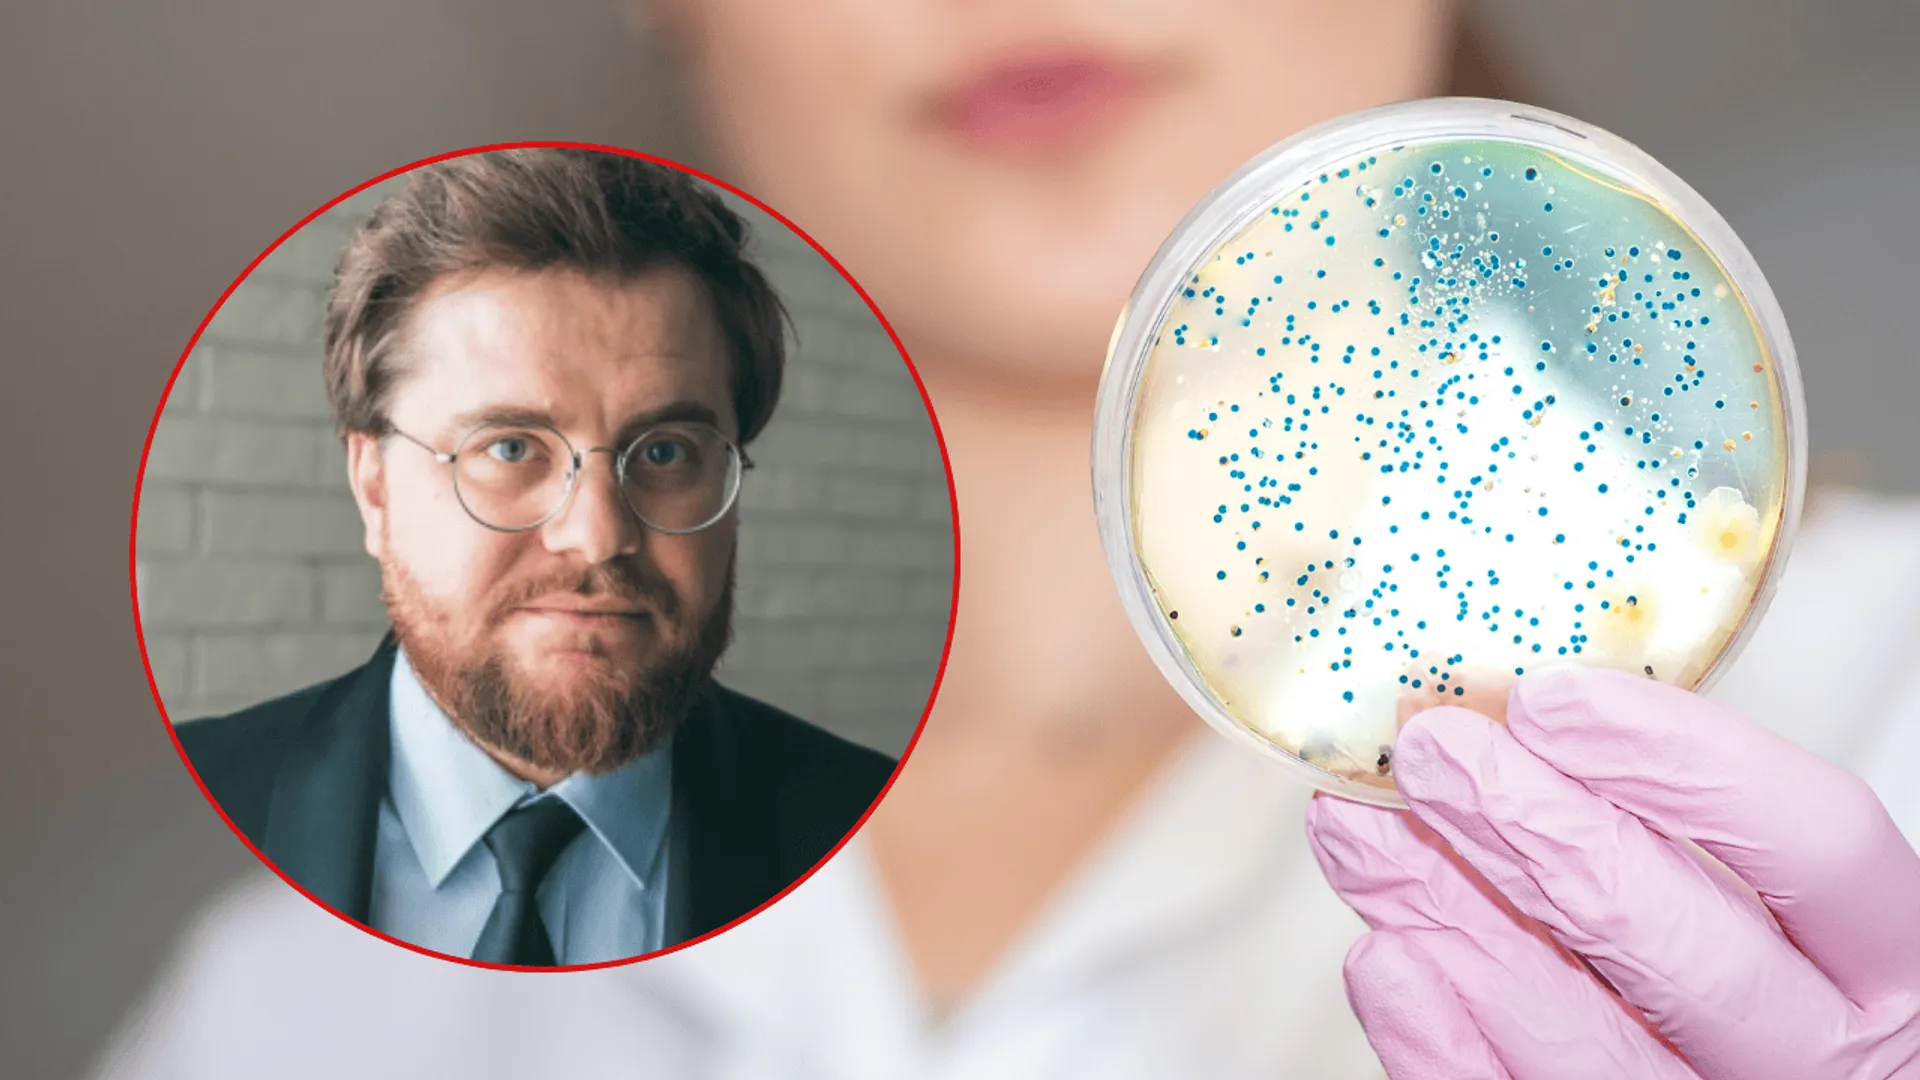

Nowy grzyb zalewa polskie lasy. Leśnicy pilnie alarmują. "To nie jest dobra wiadomość"

W szczycie sezonu grzybowego leśnicy z Nadleśnictwa Hajnówka przekazali niepokojące wieści. W rejonie Puszczy Białowieskiej pojawił się nowy, obcy gatunek grzyba. Choć dla grzybiarzy może to brzmieć jak okazja, eksperci alarmują, że jego obecność to zły sygnał.
Tych grzybów nie wkładaj do koszyka
Wybierając się do lasu, większość z nas pamięta, by nie zbierać grzybów trujących. Mało kto wie, że w Polsce obowiązuje również lista gatunków grzybów objętych ścisłą ochroną. Znajdują się na niej takie okazy jak borowik królewski, maślak trydencki czy trufla wgłębiona.
Zbieranie tych rzadkich gatunków jest nielegalne i grozi za to kara grzywny. Mandat od straży leśnej może wynieść do 500 złotych, a jeśli sprawa trafi do sądu, grzywna może wzrosnąć nawet do 5000 złotych.
W jednym z polskich rejonów pojawił się jednak nowy gatunek. Eksperci przed nim przestrzegają. Powód może zaniepokoić.

Amerykański gość w Puszczy Białowieskiej. Pojawił się nowy gatunek grzyba
Do listy grzybów, na które trzeba uważać, dołącza złotoborowik wysmukły (Aureoboletus projectellus), znany jako borowik amerykański. Jak poinformowało Nadleśnictwo Hajnówka, gatunek ten zaobserwowano w lasach Puszczy Białowieskiej.
To grzyb pochodzący z Ameryki Północnej, który od kilkunastu lat rozprzestrzenia się w Europie. Charakteryzuje się czerwonobrązowym kapeluszem oraz długim, smukłym, żółtawym trzonem.
Jego pojawienie się w tak cennym miejscu jest sygnałem, że inwazja tego gatunku postępuje bardzo szybko. Czy jednak wolno go zbierać i spożywać?
Eksperci przestrzegają przed borowikiem amerykańskim
Co ciekawe, borowik amerykański jest grzybem jadalnym i smacznym. Dlaczego więc leśnicy alarmują, że jego obecność „to nie jest dobra wiadomość”?
Zagrożenie nie dotyczy zdrowia ludzi, lecz kondycji polskich lasów. Borowik amerykański to inwazyjny gatunek obcy. Oznacza to, że konkuruje on z naszymi rodzimymi grzybami o zasoby. Jego ekspansja może w przyszłości doprowadzić do wypierania ze stanowisk tak uwielbianych przez Polaków borowików szlachetnych, podgrzybków czy koźlarzy. Apel leśników to prośba o świadome podejście do grzybobrania i zrozumienie zagrożenia dla bioróżnorodności naszych lasów.